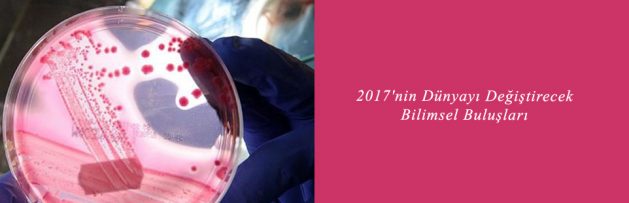

Orta Doğu Teknik Üniversitesi (ODTÜ) Kimya Bölümü Öğretim Üyesi Prof. Dr. Ural Akbulut’un çeşitli kaynaklardan yaptığı derlemeye göre, mikrobiyoloji ve immünoloji alanlarındaki buluşlar, 2017’nin bilimsel ve teknolojik gelişmelerine damgasını vurdu.
İmmünoloji
ÜÇ ETAPLI RADYOİMMÜNOTERAPİ İLE KOLON KANSER TEDAVİSİ
ABD’de MSK Kanser Merkezi ve MIT’nin ortak çalışması sonucunda geliştirilen üç etaplı radyoimmünoterapi tekniğiyle toksik bir etki olmaksızın kolorektal kanser tedavisinde yüzde 100 başarı elde edildi. Bu çalışmada, A33 tümör antijenine özgü bir antikor, lütetiyum-177 kompleksi ve özel bir organik bileşik kullanılarak glikoprotein A33 (GPA33) hedeflendi. Araştırmacıların geliştirdiği özel organik bileşiğin önemli bir rolü olduğu açıklandı.
Araştırmacılar, bu bileşiğin kanser hücrelerini bulup ardından da onları yok ederek kanseri tedavi ettiğini belirtti. Hayvan deneylerinde başarılı olan bu yöntemin insanlara uygulanabilmesi için çalışmaların başlatıldığı belirtildi. Çalışma, The Nuclear Medicine dergisinde yayımlandı.
Viroloji
SOĞUK ALGINLIĞINI TEDAVİ EDECEK VİRÜSÜN KODU ÇÖZÜLDÜ
Leeds, York ve Helsinki üniversitelerindeki araştırmacılar, soğuk algınlığının kesin tedavisinin çok yakın olduğunu açıkladı. Açıklamada, insan parechovirüsünün genetik kodu çözüldüğü için soğuk algınlığının tek bir ilaçla tedavi edilebileceği belirtildi. Buluş ile virüslerin kendilerini yenilese bile tek bir ilaç tasarlanarak soğuk algınlığının tedavi edilebileceğini gösterdiği vurgulandı. Yeni ilacın sentezlenerek testler tamamlandıktan sonra kullanılmaya başlaması için 10 yıl gerektiği aktarıldı. Çalışma, Nature Communications dergisinde yayımlandı.
Genel Mikrobiyoloji
BİR HÜCRENİN ÜZERİNDEKİ VİRÜSÜ GÖSTEREN MERCEK
Vanderbilt Üniversitesinde Doç. Dr. J. Caldwell, boron nitrür kristallerini kullanarak canlı hücreleri ve üzerlerindeki virüsleri gösteren bir hiper mercek geliştirdi. Bor nitrür kristali ile yapılan hiper mercek, nano boyuttaki canlı organizmaları inceleme olanağını doğurdu. Araştırmacılar, merceğin insan saçının üç binde birine karşılık gelen 30 nanometre boyuttaki objeleri görüntüleyecek şekilde geliştirileceğini açıkladı. Çalışma, Nature Materials dergisinde yayımlandı.
Endüstriyel Mikrobiyoloji
YARI İLETKENLERLE KAPLANAN BAKTERİLER, GÜNEŞ IŞINIYLA YAKIT ÜRETTİ
Berkeley ve Harvard üniversiteleri araştırmacılardan Dr. P. Yang ve Dr. K. Sakimoto, bakterilerin dış yüzeyini yarı iletken madde ile kaplamayı başardı. Bu bakteriler, güneş enerjisini emerek yakıt olabilecek organik madde üretti. Bu çalışmada, bazı bakterilerin kadmiyum gibi ağır metalleri kükürtlü bileşiklere dönüştürme özelliğinden yararlanıldı. Araştırmacılar, besin ekledikleri suda bakterileri çoğalttıktan sonra karışıma kadmiyum tuzu kattıklarını ve bir süre sonra bakterilerin yüzeyinin kadmiyum sülfürle kaplandığını açıkladılar. Yüzeyi kadmiyum sülfürle kaplı bakteriler, güneş ışınları yardımıyla su ve karbondioksitten asetik asit üretti. Asetik asit üretimindeki veriminin yüzde 80 olduğu açıklandı. Çalışma, Washington’daki ACS Konferansı’nda sunuldu.
Endüstriyel Mikrobiyoloji
MİKROBİYAL YAKIT PİLİNDE YENİLİK
SUNY-Birmingham Üniversitesinden Yrd. Doç. Dr. S. Choi, birbirine destek veren iki ayrı bakteri türünü kullanarak yeni bir mikrobiyal yakıt pili geliştirdi. S. Choi, iki tür bakterinin olduğu çözelti güneş ışınları altındayken, çözeltiye biraz besin eklediklerini açıkladı. Besin eklenince, heterotrofik bakteriler çoğalıp karbondioksit üretmeye başladı. Karbondioksit, fototrofik bakterilerce kullanılmaya başlanıp simbiyotik bir düzen kurulunca S. Choi, heterotrofik bakterilere besin eklemeyi kesti. Pil, besin eklemeye gerek kalmadan 13 gün çalıştı ve 8 mikroamper/santimetrekare akım üretti. Çalışma, Power Sources dergisinde yayımlandı.
![]()
Haberi için [Tıklayınız]